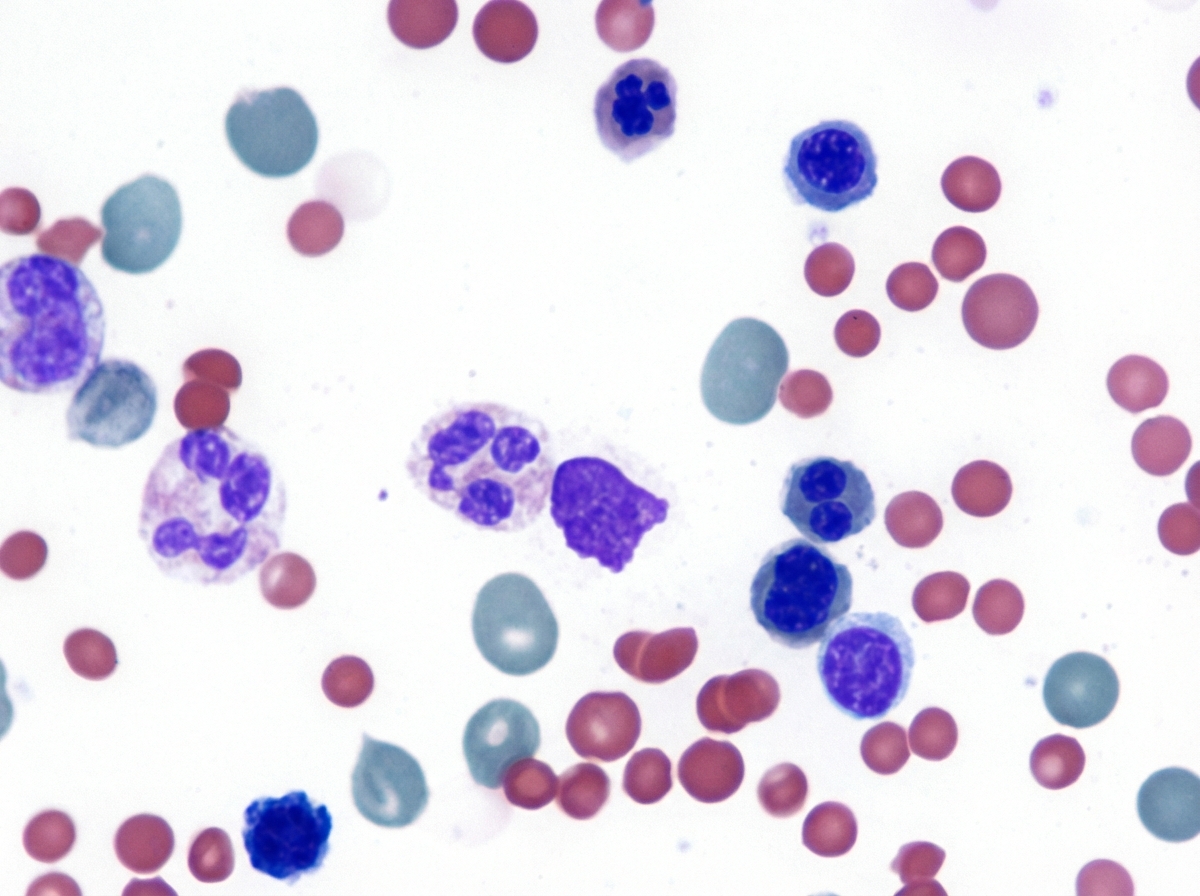
Image for question 36

Liver disease — MCQs

On this page
A 57-year-old man is brought to the emergency department by his family because of several episodes of vomiting of blood in the past 24 hours. He has a history of alcoholic cirrhosis and is being treated for ascites with diuretics and for encephalopathy with lactulose. His vital signs include a temperature of 36.9°C (98.4°F), pulse of 85/min, and blood pressure of 80/52 mm Hg. On examination, he is confused and unable to give a complete history. He is noted to have jaundice, splenomegaly, and multiple spider angiomas over his chest. Which of the following is the best initial management of this patient?
A 38-year-old woman comes to the physician because of a 3-month history of moderate abdominal pain that is unresponsive to medication. She has a history of two spontaneous abortions at 11 and 12 weeks' gestation. Ultrasound examination of the abdomen shows normal liver parenchyma, a dilated portal vein, and splenic enlargement. Upper endoscopy shows dilated submucosal veins in the lower esophagus. Further evaluation of this patient is most likely to show which of the following findings?
A 59-year-old man with a history of alcoholic cirrhosis is brought to the physician by his wife for a 1-week history of progressive abdominal distension and yellowing of the eyes. For the past month, he has been irritable, had difficulty falling asleep, become clumsy, and fallen frequently. Two months ago he underwent banding for esophageal varices after an episode of vomiting blood. His vital signs are within normal limits. Physical examination shows jaundice, multiple bruises, pedal edema, gynecomastia, loss of pubic hair, and small, firm testes. There are multiple small vascular lesions on his chest and neck that blanch with pressure. His hands are erythematous and warm; there is a flexion contracture of his left 4th finger. A flapping tremor is seen on extending the forearms and wrist. Abdominal examination shows dilated veins over the anterior abdominal wall, the spleen tip is palpated 4 cm below the left costal margin, and there is shifting dullness on percussion. Which of the following physical examination findings are caused by the same underlying pathophysiology?
A 55-year-old man comes to the physician for a follow-up examination. During the past month, he has had mild itching. He has alcoholic cirrhosis, hypertension, and gastroesophageal reflux disease. He used to drink a pint of vodka and multiple beers daily but quit 4 months ago. Current medications include ramipril, esomeprazole, and vitamin B supplements. He appears thin. His temperature is 36.8°C (98.2°F), pulse is 68/min, and blood pressure is 115/72 mm Hg. Examination shows reddening of the palms bilaterally and several telangiectasias over the chest, abdomen, and back. There is symmetrical enlargement of the breast tissue bilaterally. His testes are small and firm on palpation. The remainder of the examination shows no abnormalities. Laboratory studies show: Hemoglobin 10.1 g/dL Leukocyte count 4300/mm3 Platelet count 89,000/mm3 Prothrombin time 11 sec (INR = 1) Serum Albumin 3 g/dL Bilirubin Total 2.0 mg/dL Direct 0.2 mg/dL Alkaline phosphatase 43 U/L AST 55 U/L ALT 40 U/L α-Fetoprotein 8 ng/mL (N < 10) Anti-HAV IgG antibody positive Anti-HBs antibody negative Abdominal ultrasonography shows a nodular liver surface with atrophy of the right lobe of the liver. An upper endoscopy shows no abnormalities. Which of the following is the most appropriate next step in management?
A 54-year-old man comes to the emergency department because of abdominal distension for the past 3 weeks. He also complains of generalized abdominal discomfort associated with nausea and decreased appetite. He was discharged from the hospital 3 months ago after an inguinal hernia repair with no reported complications. He has a history of type 2 diabetes mellitus, congestive heart failure, and untreated hepatitis C. His current medications include aspirin, atorvastatin, metoprolol, lisinopril, and metformin. His father has a history of alcoholic liver disease. He has smoked one pack of cigarettes daily for 30 years but quit 5 years ago. He drinks 3–4 beers daily. He appears cachectic. His vital signs are within normal limits. Examination shows a distended abdomen and shifting dullness. There is no abdominal tenderness or palpable masses. There is a well-healed surgical scar in the right lower quadrant. Examination of the heart and lung shows no abnormalities. He has 1+ bilateral lower extremity nonpitting edema. Diagnostic paracentesis is performed. Laboratory studies show: Hemoglobin 10 g/dL Leukocyte count 14,000/mm3 Platelet count 152,000/mm3 Serum Total protein 5.8 g/dL Albumin 3.5 g/dL AST 18 U/L ALT 19 U/L Total bilirubin 0.8 mg/dL HbA1c 8.1% Peritoneal fluid analysis Color Cloudy Cell count 550/mm3 with lymphocytic predominance Total protein 3.5 g/dL Albumin 2.6 g/dL Glucose 60 mg/dL Triglycerides 360 mg/dL Peritoneal fluid Gram stain is negative. Culture and cytology results are pending. Which of the following is the most likely cause of this patient's symptoms?
A 28-year-old man presents with a yellow coloration of his skin. He says he feels well and denies any recent history of nausea, fatigue or fever, or discoloration of his urine or stool. The patient reports episodes with similar symptoms in the past. Family history is significant for similar symptoms in his father. The patient is afebrile and vital signs are within normal limits. On physical examination, he is jaundiced. Scleral icterus is present. Laboratory findings are significant only for an unconjugated hyperbilirubinemia. Liver enzymes are normal, and there is no bilirubin present in the urine. Which of the following is the most appropriate treatment for this patient’s most likely diagnosis?
A 60-year-old man is brought to your medical office by his daughter, who noticed that he has had a progressive increase in breast size over the past 6 months. The patient does not complain of anything else except easy fatigability and weakness. His daughter adds that he does not have a good appetite as in the past. He has occasional discomfort and nipple sensitivity when he puts on a tight shirt. The medical history is significant for benign prostatic hyperplasia for which he takes tamsulosin. The patient also admits that he used to take anti-hypertensive medications, but stopped because his blood pressure had normalized. On physical examination, the pulse is regular at 78/min, the respirations are regular, the blood pressure is 100/68 mm Hg, and the temperature is 37.0°C (98.6°F). Examination of the chest reveals multiple vascular lesions consisting of central pinpoint red spots with red streaks radiating from a central lesion and bilaterally enlarged breast tissue. You also notice a lack of hair on the chest and axillae. There is no hepatosplenomegaly on abdominal palpation. What is the most likely cause of gynecomastia in this patient?
A previously healthy 39-year-old man comes to the physician because of a 1-month history of fatigue and red-colored urine. His vital signs are within normal limits. Physical examination shows pallor and jaundice. His platelet count is 90,000/mm3 and creatinine concentration is 1.0 mg/dL. A direct Coombs test is negative. Flow cytometry shows erythrocytes deficient in CD55 and CD59 surface antigens. This patient is at greatest risk for which of the following complications?
A 35-year-old woman with a history of systemic lupus erythematosus (SLE) presents with worsening fatigue. She says her symptoms onset a few months ago and are significantly worse than experienced due to her SLE. Past medical history is significant for SLE diagnosed 3 years ago, managed with NSAIDs and hydroxychloroquine. A review of systems is significant for abdominal pain after meals, especially after eating fast food. Her vitals include: temperature 37.0°C (98.6°F), blood pressure 100/75 mm Hg, pulse 103/min, respirations 20/min, and oxygen saturation 99% on room air. On physical examination, the patient appears pale and tired. The cardiac exam is normal. The abdominal exam is significant for prominent splenomegaly. Scleral icterus is noted. Skin appears jaundiced. Laboratory tests are pending. A peripheral blood smear is shown in the exhibit. Which of the following is the best course of treatment for this patient’s fatigue?
A 47-year-old Caucasian woman presents with a 2-month history of general fatigue, slight jaundice, and mild itching. She has also noticed that her urine has been darker and stools have been lighter in color recently. She denies any fevers, chills, or alcohol use. She has no significant past medical or surgical history and is not taking any medications. She recalls that her mother saw a doctor for eye and mouth dryness but cannot remember the name of her diagnosis. She denies any illicit drug use, recent change in diet, or recent travel. On physical exam, her abdomen is soft and non-distended. There is right upper quadrant tenderness to deep palpation but a negative Murphy’s sign. Her laboratory findings were significant for increased liver enzymes, direct bilirubin, and alkaline phosphatase with normal levels of iron and ceruloplasmin. Ultrasound revealed no stones in the gallbladder or common bile duct and endoscopic retrograde cholangiopancreatography (ERCP) revealed normal extrahepatic biliary ducts. Which of the following findings is most likely to also be found in this patient?
Practice by Chapter
Viral hepatitis (A, B, C, D, E)
Practice Questions
Alcoholic liver disease
Practice Questions
Non-alcoholic fatty liver disease
Practice Questions
Drug-induced liver injury
Practice Questions
Autoimmune hepatitis
Practice Questions
Cirrhosis management
Practice Questions
Portal hypertension complications
Practice Questions
Ascites diagnosis and management
Practice Questions
Hepatic encephalopathy
Practice Questions
Spontaneous bacterial peritonitis
Practice Questions
Hepatorenal syndrome
Practice Questions
Hepatocellular carcinoma
Practice Questions
Liver transplantation
Practice Questions
Want unlimited practice?
Get full access to all questions, explanations, and performance tracking.
Scan to download app
